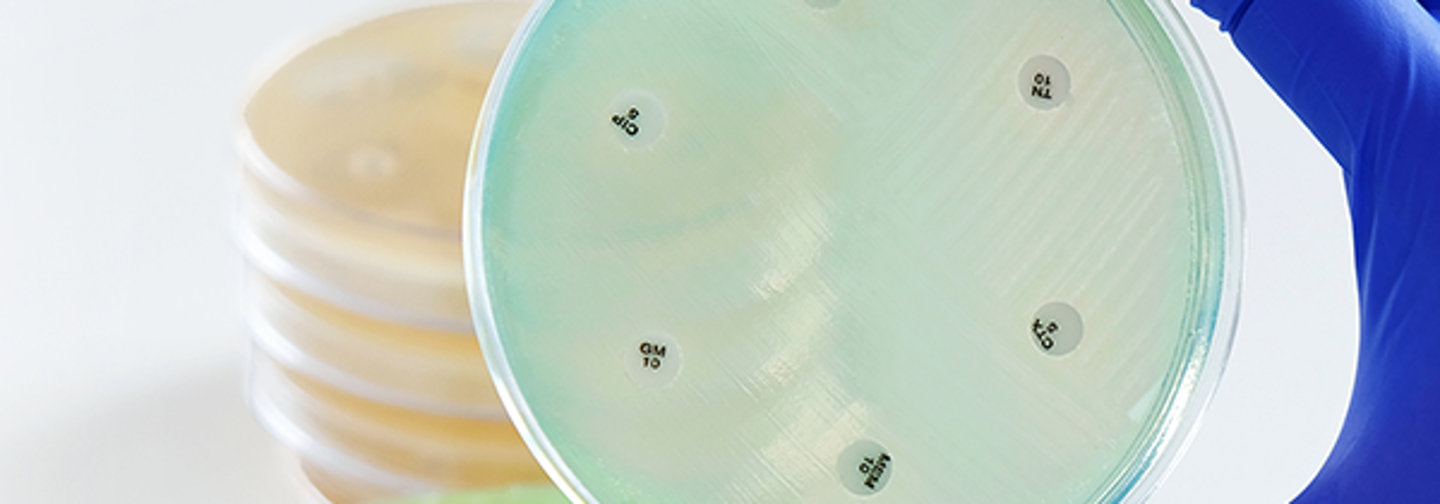
AST

AST
Antimicrobial Susceptibility Testing (AST) plays a vital role in guiding effective antimicrobial therapy and combating antimicrobial resistance. Accurate AST supports informed treatment decisions for bacterial and fungal infections and is essential in modern clinical microbiology.
Mast Group is a pioneer in AST, with over 65 years of experience developing trusted, high-quality susceptibility testing products. Built on a legacy of innovation, quality, and collaboration with the pharmaceutical industry, Mast remains committed to advancing AST solutions that meet evolving clinical and regulatory demands

Pioneers in AST
Today, Mast offers a comprehensive and expanding range of AST products, including MASTDISCS® AST, MASTRING-S® and ADATAB®. These manual testing solutions support susceptibility and MIC determination using disc diffusion and multipoint technology, in accordance with international standards such as Clinical and Laboratory Standards Institute (CLSI) and The European Committee on Antimicrobial Susceptibility Testing (EUCAST).
Popular Products

More InfoASTAMPICILLIN 10ug Cartridge discsIndividual antimicrobial susceptibility test discs in plastic dispensing cartridges containing Ampicillin 10ug
More InfoASTAmoxicillin 3.2mg ADATAB®Freeze dried supplement containing Amoxicillin 3.2mg for agar dilution susceptibility testing.
More InfoASTAMOXICILLIN 25ug Cartridge discsIndividual antimicrobial susceptibility test discs in plastic dispensing cartridges containing Amoxicillin 25ug
More InfoASTMAST® DISCMASTER 6-Place DispenserThe MAST® DISCMASTER 6-Place Dispenser is a reliable and robust hand operated device for the dispensing of AST, ID and combination discs within the MASTDISCS® range.